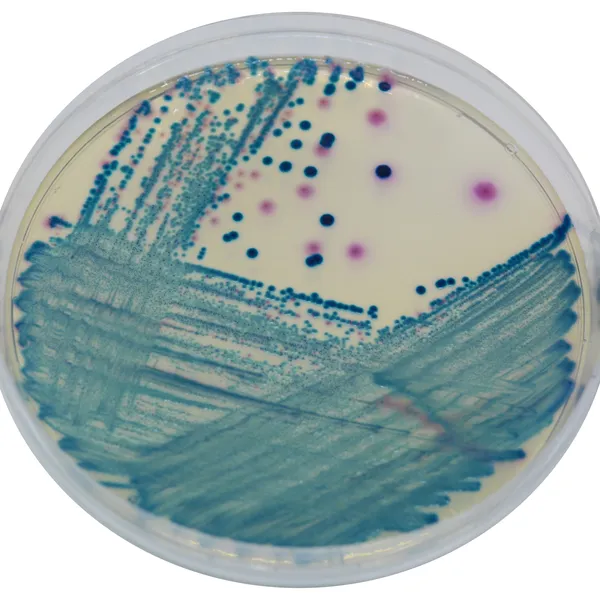
CHROMagar™ mSuperCARBA™

Colonies Appearance

CPE E. coli
dark pink to reddish

CPE Klebsiella, Enterobacter, Citrobacter
metallic blue

CPO Pseudomonas
translucent cream to blue

CPO Acinetobacter
cream, opaque
Performance
Performance
CDC: «Carbapenem-resistant Enterobacteriaceae (CRE) are usually resistant to all β-lactam agents as well as most other classes of antimicrobial agents. The treatment options for patients infected with CRE are very limited. Healthcare-associated outbreaks of CRE have been reported. Patients colonized with CRE are thought to be a source of transmission in the healthcare setting. Identifying patients who are colonized with CRE and placing these patients in isolation precautions may be an important step in preventing transmission».
CHROMagar™ launched in 2007 the first chromogenic medium for the detection of carbapenem-resistant bacteria, particularly targeting KPC-enzymes. Since then, many other carbapenemases have been spreading around the world and therefore there was a need to address today the difficult detection of low level carbapemases.
Alain Rambach and Patrice Nordmann have joined their efforts to develop a highly sensitive chromogenic medium, CHROMagar™ mSuperCARBA™, the new generation of chromogenic media that reaches unprecedented performances: detection of a large variety of carbapenemases KPC, NDM, VIM, IMP, OXA…with an impressive limit of detection (10 CFU/mL) even for weakly expressed carbapenemases like OXA-48, while maintaining a high level of selectivity.
Intended Use :
CHROMagar™ mSuperCARBA™ is a selective and differential chromogenic culture medium, intended for use in the qualitative direct detection of gastrointestinal colonization with carbapenem-resistant Enterobacteria (CRE), including OXA-48 producers, to aid in the prevention and control of CRE in healthcare settings. The test is performed with rectal swab and stools from patients to screen for CRE colonization. Results can be interpreted after 18-24 h of aerobic incubation at 35-37 °C.
CHROMagar™ mSuperCARBA™ is not intended to diagnose CRE infection nor to guide nor monitor treatment for infections. A lack of growth or the absence of colonies on CHROMagar™ mSuperCARBA™ does not preclude the presence of CRE. Further identification, susceptibility testing, and epidemiological typing is needed on suspect colonies.
Composition
 <img class="vce-single-image" src="/Composition-EN-1756865886.png" width="690" height="380" alt="" title="Composition EN" />
<img class="vce-single-image" src="/Composition-EN-1756865886.png" width="690" height="380" alt="" title="Composition EN" /> Technical Documents
Scientific Publications
2025
Evaluation of Chromogenic Medium for the Detection and Isolation of Carbapenem-Resistant Organisms from Perirectal Swabs
📄 Publication2023
Dissemination of carbapenemase-producing Enterobacterales through wastewater and gulls at a wastewater treatment plant in Sweden
📄 Publication2023
Intraregional hospital outbreak of OXA-244-producing Escherichia coli ST38 in Norway, 2020
📄 Publication2022
Genomic landscape of blaGES-5- and blaGES-24-harboring Gram-negative bacteria from hospital wastewater: emergence of class 3 integron-associated blaGES-24 genes
📄 Publication2022
Multidrug resistant bacteria on air, inanimate surface and medical equipment in an intensive care unit in Lima, Peru
📄 Publication2022
Surveillance and Control Efforts for Carbapenemase-Producing Gram-Negatives at a High Burden Vietnam University Hospital (abstract)
📄 Publication2022
A European multicenter evaluation study to investigate the performance on commercially available selective agar plates for the detection of carbapenemase producing Enterobacteriaceae
📄 Publication2021
Evidence of widespread endemic populations of highly multidrug-resistant Klebsiella pneumoniae seen concurrently through the lens of two hospital intensive care units in Vietnam
📄 Publication2021
Performance evaluation of screening medium for carbapenemase-producing Enterobacterales
📄 Publication2021
A prospective multicentre surveillance study to investigate the risk associated with contaminated sinks in the intensive care unit
📄 Publication2020
A genomic epidemiology study of multidrug-resistant Escherichia coli, Klebsiella pneumoniae and Acinetobacter baumannii in two intensive care units in Hanoi, Vietnam
📄 Publication2020
Environmental Presence and Genetic Characteristics of Carbapenemase-Producing Enterobacteriaceae from Hospital Sewage and River water in the Philippines
📄 Publication2020
Oral colonisation by antimicrobial-resistant Gram negative bacteria among long-term care facility residents: prevalence, risk factors and molecular epidemiology
📄 Publication2019
CHROMagar ESBL / mSuperCARBA bi-plate medium for detection of ESBL and carbapenemase-producing Enterobacteriaceae from spiked tools
📄 Publication2019
Evaluation of CHROMagar mSuperCARBA as a phenotypic test for detection of carbapenemase producing organisms
📄 Publication2018
Utility of CHROMagar mSuperCARBA for surveillance cultures of carbapenemase-producing Enterobacteriaceae
📄 Publication2018
Validation of Colorex™ ESBL/mSuperCARBA™ bi-plate on WASP®/WASPLab® to screen for ESBL and CPE
📄 Publication2018
Utility of CHROMagar mSuperCARBA for surveillance cultures of carbapenemase-producing Enterobacteriaceae
📄 Publication2018
Evaluation of carbapenemase-producing Enterobacteriaceae screening using CHROMagar™ mSuperCARBA™
📄 Publication2017
Dépistage du portage digestif d`entérobactéries productrices de carbapénemases (EPC) dans l Algérois durant l année 2016
📄 Publication2017
Comparative evaluation of a new commercial media, the CHROMAgar™ mSuperCARBA™, for the detection of carbapenemase-producing Enterobacteriaceae
📄 Publication2017
Evaluation of a new commercial medium, the CHROMagar mSuperCARBA, for the detection of carbapenemase-producing Enterobacteriaceae
📄 Publication2017
Amélioration de la détection des entérobactéries productrices de carbapénémase (EPC)
📄 Publication2016
Evaluation of different media for introduction of a CPE screening program at a UK hospital.
📄 Publication2016
CHROMagar mSuperCarba screening followed by Rapidec Carba NP test for detection of carbapenemase producers in Enterobacteriaceae
📄 Publication2016
CHROMagar mSuperCARBA performance in carbapenem-resistant Enterobacteriaceae isolates characterized at molecular level and routine surveillance rectal swab specimens
📄 Publication2016
Evaluation of CHROMagar™mSuperCARBA™ for the detection of carbapenemase producing Gram-negative organisms
📄 Publication2016
CHROMagar SuperCarba, un nuevo medio cromogénico-selectivo para la detección de organismos productores de carbapenemasas (CPO)
📄 Publication

Read more